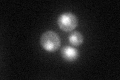
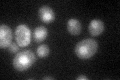

View description
Protein that interacts with Cdc48p and Npl4p, involved in recognition of polyubiquitinated proteins and their presentation to the 26S proteasome for degradation; involved in transporting proteins from the ER to the cytosol
Localization:
Intensity:
Fold change:
Significance:
-
C’ GFP library in SD
nucleus:cytosol42.97 -
N' NOP1pr-GFP in SD

cytosol,nucleus78.5971 -
N' TEF2pr-mCherry in SD

cytosol,nucleus132.245 -
N' NATIVEpr-GFP in SD

cytosol,nucleus29.6091 -
N' TEF2pr-VC and Cyto-VN in SD

nucleus40.22 -
C’ GFP library in SD+DTT

nucleus.cytosol47.931.11No -
C’ GFP library in SD+H2O2

nucleus.cytosol51.061.18No -
C’ GFP library in Starvation Media
nucleus,cytosol66.841.55Yes -
C’ GFP library on the background of Pup2-DaMP

nucleus:cytosol -
C’ GFP library on the background of CCT mutant

nucleus:cytosol48.50271.12854No
